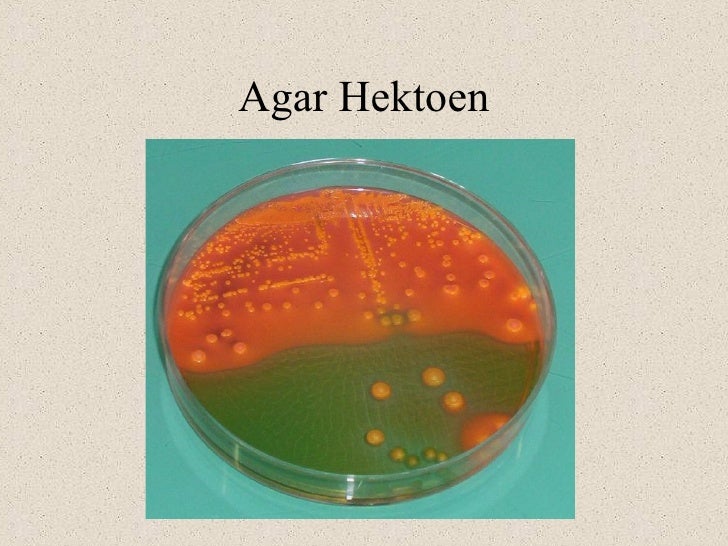
Enterobacterias

Salmonella Vs Shigella Symptoms / Microbiology Atlas of Gastrointestinal Infections and ... / Selective agar is not diagnostic.
Salmonella Vs Shigella Symptoms / Microbiology Atlas of Gastrointestinal Infections and ... / Selective agar is not diagnostic.. Cause of typhi salmonellosis (typhi fever, paratyphi a, b and c), salmonella enterica serotype typhi or paratyphi a, b and c include salmonella to the family of enterobacteriaceae. Selective agar is not diagnostic. „shigellosis is endemic throughout the world where it is held responsible for some 120 million cases of severe dysentery with blood and mucus in the stools, the overwhelming majority of which occur in. Salmonella senftenberg infections , serbia. Salmonella infection (salmonellosis) affects the intestinal tract.
Ct findings in four patients. Diarrhea may last up to 10 days, although it may take several months before. What clinical symptoms do you see with shigella dysenteriae? • daha sonraki yıllarda s.sonnei predominan hale geldi. Most people with a salmonella infection experience:

Sudden onset of abdominal pain, fever, watery diarrhea.
Шигеллы, эшерихии, сальмонеллы, кампилобактерии, днк (shigella spp., e. Serotypes salmonella typhimurium, salmonella enteritidis , salmonella newport , and salmonella heidelberg are most often responsible for food poisoning; „shigellosis is endemic throughout the world where it is held responsible for some 120 million cases of severe dysentery with blood and mucus in the stools, the overwhelming majority of which occur in. Symptoms of salmonellosis are relatively mild and patients will make a recovery without specific treatment in most cases. Selective agar is not diagnostic. Sudden onset of abdominal pain, fever, watery diarrhea. The differences and similarities between salmonella and shigella are as follows: What clinical symptoms do you see with shigella dysenteriae? Learn more about the causes, treatment and prevention of this common signs and symptoms of salmonella infection generally last two to seven days. Symptoms of salmonella include diarrhea (can be bloody), fever, and stomach cramps. Salmonella infection affects the small and large intestine (enterocolitis) where as shigella infection affects the colon (colitis). • daha sonraki yıllarda s.sonnei predominan hale geldi. Diarrhea may last up to 10 days, although it may take several months before.
Serotypes salmonella typhimurium, salmonella enteritidis , salmonella newport , and salmonella heidelberg are most often responsible for food poisoning; Symptoms of salmonellosis are relatively mild and patients will make a recovery without specific treatment in most cases. Call the doctor for diarrhea lasting over 3 days, signs of dehydration, and fever symptoms. Coli (eiec), salmonella spp., campylobacter spp., пцр) кал, кач. Learn more about the causes, treatment and prevention of this common signs and symptoms of salmonella infection generally last two to seven days.

• i̇nsan ve hayvanlarda yaşamaya adapte olmuş 2300'den fazla serotip.
Shigella boydii (shigellosis, bacillary dysentery). Most people with a salmonella infection experience: The differences and similarities between salmonella and shigella are as follows: Call the doctor for diarrhea lasting over 3 days, signs of dehydration, and fever symptoms. Salmonella and shigella are two genera within the family enterobacteriaceae. Symptoms of salmonellosis are relatively mild and patients will make a recovery without specific treatment in most cases. „shigellosis is endemic throughout the world where it is held responsible for some 120 million cases of severe dysentery with blood and mucus in the stools, the overwhelming majority of which occur in. Salmonellosis and shigellosis are more likely to occur in children under 5 years of age and the elderly. Salmonella infection (salmonellosis) affects the intestinal tract. What clinical symptoms do you see with shigella dysenteriae? Diarrhea (that can be bloody). Diarrhea may last up to 10 days, although it may take several months before. Cause of typhi salmonellosis (typhi fever, paratyphi a, b and c), salmonella enterica serotype typhi or paratyphi a, b and c include salmonella to the family of enterobacteriaceae.
Most people with a salmonella infection experience: What is the h2s production of shigella vs. Symptoms of salmonellosis are relatively mild and patients will make a recovery without specific treatment in most cases. Serotypes salmonella typhimurium, salmonella enteritidis , salmonella newport , and salmonella heidelberg are most often responsible for food poisoning; • 1995'e kadar s.flexnerii predominan.
The differences and similarities between salmonella and shigella are as follows:
Most people with a salmonella infection experience: • i̇nsan ve hayvanlarda yaşamaya adapte olmuş 2300'den fazla serotip. Diarrhea, abdominal pain and fever are the main symptoms in. Coli (eiec), salmonella spp., campylobacter spp., пцр) кал, кач. • daha sonraki yıllarda s.sonnei predominan hale geldi. Salmonellosis and shigellosis are more likely to occur in children under 5 years of age and the elderly. Serotypes salmonella typhimurium, salmonella enteritidis , salmonella newport , and salmonella heidelberg are most often responsible for food poisoning; Shigella boydii (shigellosis, bacillary dysentery). Salmonella infection (salmonellosis) affects the intestinal tract. Sudden onset of abdominal pain, fever, watery diarrhea. Salmonella senftenberg infections , serbia. Шигеллы, эшерихии, сальмонеллы, кампилобактерии, днк (shigella spp., e. Learn more about the causes, treatment and prevention of this common signs and symptoms of salmonella infection generally last two to seven days.
Komentar
Posting Komentar